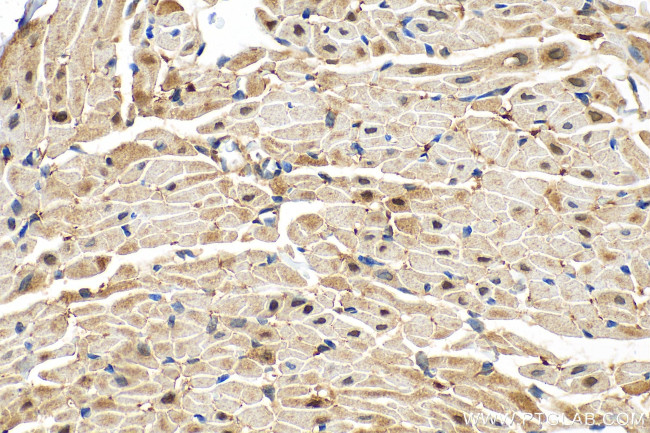
PTPN11 Antibody in Immunohistochemistry (Paraffin) (IHC (P))

Search
Proteintech
PTPN11 Recombinant Rabbit Monoclonal Antibody (5L23)
{{$productOrderCtrl.translations['antibody.pdp.commerceCard.promotion.promotions']}}
{{$productOrderCtrl.translations['antibody.pdp.commerceCard.promotion.viewpromo']}}
{{$productOrderCtrl.translations['antibody.pdp.commerceCard.promotion.promocode']}}: {{promo.promoCode}} {{promo.promoTitle}} {{promo.promoDescription}}. {{$productOrderCtrl.translations['antibody.pdp.commerceCard.promotion.learnmore']}}
产品信息
82503-1-RR
种属反应
宿主/亚型
Expression System
分类
类型
克隆号
抗原
偶联物
形式
纯化类型
保存液
内含物
保存条件
运输条件
产品详细信息
Immunogen sequence: MTSRRWFHPN ITGVEAENLL LTRGVDGSFL ARPSKSNPGD FTLSVRRNGA VTHIKIQNTG DYYDLYGGEK FATLAELVQY YMEHHGQLKE KNGDVIELKY PLNCADPTSE RWFHGHLSGK EAEKLLTEKG KHGSFLVRES QSHPGDFVLS VRTGDDKGES NDGKSKVTHV MIRCQELKYD VGGGERFDSL TDLVEHYKKN PMVETLGTVL QLKQPLNTTR INAAEIESRV RELSKLAETT DKVKQGFWEE FETLQQQECK LLYSRKEGQR QENKNKNRYK NILPFDHTRV VLHDGDPNEP VSDYINANII MPEFETKCNN SKPKKSYIAT QGCLQNTVND FWRMVFQENS RVIVMTT
靶标信息
The protein encoded by this gene is a member of the protein tyrosine phosphatase (PTP) family. PTPs are known to be signaling molecules that regulate a variety of cellular processes including cell growth, differentiation, mitotic cycle, and oncogenic transformation. This PTP contains two tandem Src homology-2 domains, which function as phospho-tyrosine binding domains and mediate the interaction of this PTP with its substrates. This PTP is widely expressed in most tissues and plays a regulatory role in various cell signaling events that are important for a diversity of cell functions, such as mitogenic activation, metabolic control, transcription regulation, and cell migration. Mutations in this gene are a cause of Noonan syndrome as well as acute myeloid leukemia.
仅用于科研。不用于诊断过程。未经明确授权不得转售。
篇参考文献 (0)
生物信息学
蛋白别名: encodes catalytic domain; HCP; HGNC:9644; MGC14433; Noonan syndrome 1; null; OTTHUMP00000166108; protein tyrosine phosphatase SH-PTP2; Protein-tyrosine phosphatase 1D; Protein-tyrosine phosphatase 2C; Protein-tyrosine phosphatase SYP; PTP-1D; PTP-2C; PTP1C; SH-PTP2; SH-PTP2 protein tyrosine phosphatase non-receptor type 11; SH-PTP2 protein tyrosine phosphatase, non-receptor type 11; SH-PTP3; SH2 domain-containing protein tyrosine phosphatase-2; SHP-2; Tyrosine-protein phosphatase non-receptor type 11
基因别名: 2700084A17Rik; AW536184; BPTP3; CFC; JMML; METCDS; NS1; PTP-1D; PTP1D; PTP2C; PTPN11; SAP-2; SH-PTP2; SH-PTP3; SHP-2; SHP2; SHPTP2; Syp
UniProt ID: (Human) Q06124, (Mouse) P35235, (Rat) P41499
Entrez Gene ID: (Human) 5781, (Mouse) 19247, (Rat) 25622